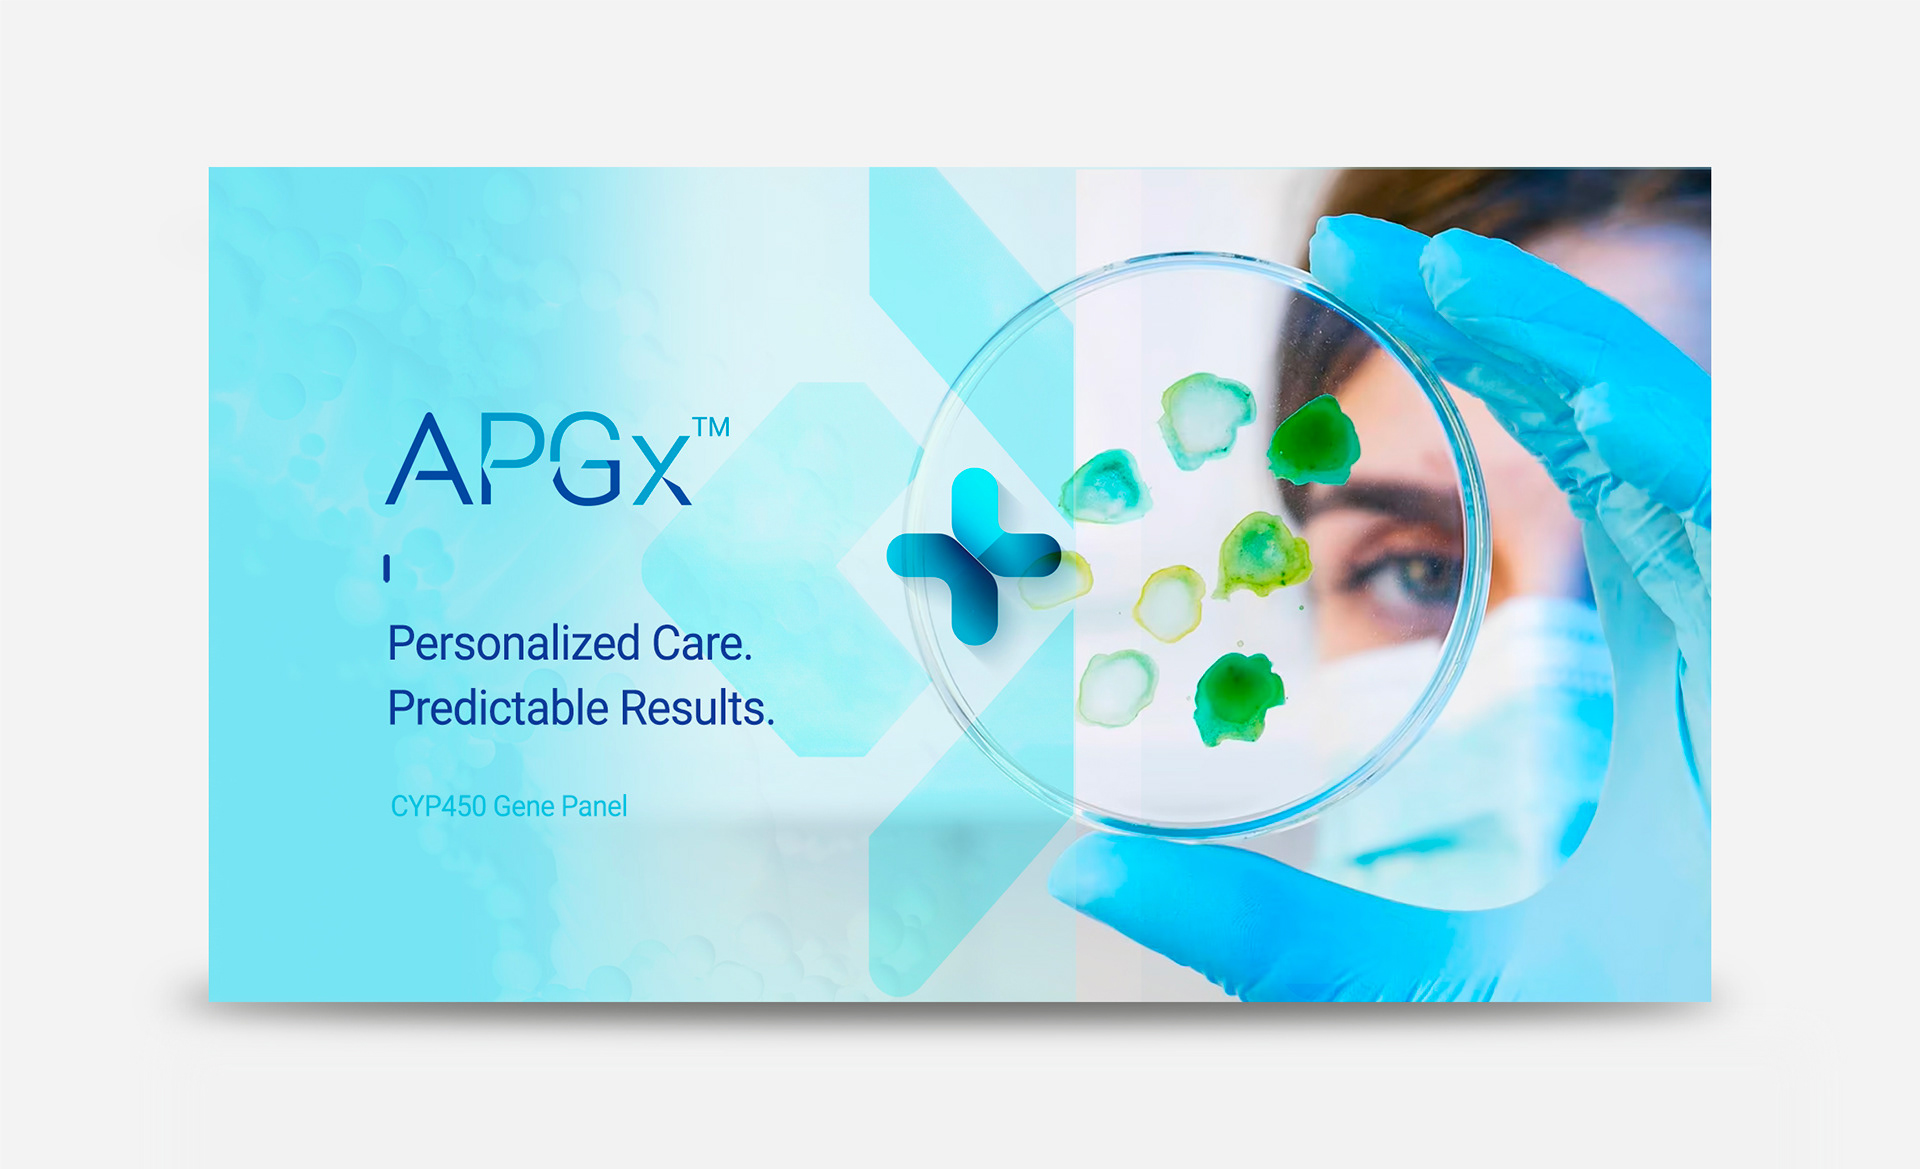

Pharmacogenomics is a discipline that most patients and physicians have never heard of, which makes communication both harder and more important.
I designed a brand identity that translates precision medicine into visual clarity: credible enough for clinicians, accessible enough for patients, and distinctive enough to stand out in a clinical market that defaults
to sameness.
I designed a brand identity that translates precision medicine into visual clarity: credible enough for clinicians, accessible enough for patients, and distinctive enough to stand out in a clinical market that defaults
to sameness.
CLIENT ▸ Acutis Diagnostics, Hicksville, NY, USA
ROLE ▸ Art Director Freelance
SCOPE ▸ Logo Design, Branding, Visual Identity, Print & Digital assets, Marketing Materials
ROLE ▸ Art Director Freelance
SCOPE ▸ Logo Design, Branding, Visual Identity, Print & Digital assets, Marketing Materials
The Challenge
Develop a credible, modern identity for a pharmacogenomics laboratory operating in a highly technical, regulated space
Translate complex genomic science into a clear, trustworthy brand language
Differentiate the lab within a competitive healthcare and biotech environment
Develop a credible, modern identity for a pharmacogenomics laboratory operating in a highly technical, regulated space
Translate complex genomic science into a clear, trustworthy brand language
Differentiate the lab within a competitive healthcare and biotech environment
Strategic Approach
Position APGx at the intersection of precision science and patient-centered care
Build a disciplined visual system reflecting accuracy, structure, and clarity
Prioritize readability, hierarchy, and scalability across clinical, sales, and digital applications
Position APGx at the intersection of precision science and patient-centered care
Build a disciplined visual system reflecting accuracy, structure, and clarity
Prioritize readability, hierarchy, and scalability across clinical, sales, and digital applications
Creative Solution
A clean, structured identity rooted in typographic precision and restrained color logic
A visual language inspired by data, structure, and molecular systems—without becoming literal or cliché
A brand framework that communicates authority while remaining accessible
A clean, structured identity rooted in typographic precision and restrained color logic
A visual language inspired by data, structure, and molecular systems—without becoming literal or cliché
A brand framework that communicates authority while remaining accessible
Scope & System
Logo and core identity architecture
Defined typographic hierarchy for reports, presentations, and digital content
Structured grid system for scientific documentation and marketing materials
Color and graphic rules designed for clarity in clinical environments
Logo and core identity architecture
Defined typographic hierarchy for reports, presentations, and digital content
Structured grid system for scientific documentation and marketing materials
Color and graphic rules designed for clarity in clinical environments
Deliverables
+ Logo and visual identity system
+ Brand guidelines and typographic framework
+ Clinical report templates
+ Sales and marketing collateral
+ Website visual direction
+ Logo and visual identity system
+ Brand guidelines and typographic framework
+ Clinical report templates
+ Sales and marketing collateral
+ Website visual direction
Role & Leadership
Brand Design Lead
Defined the identity architecture for a precision medicine company, aligning scientific authority with investor-ready and clinical communication systems.
Brand Design Lead
Defined the identity architecture for a precision medicine company, aligning scientific authority with investor-ready and clinical communication systems.
On The Work
In pharmacogenomics, trust is everything.
Design must communicate precision, clarity, and credibility without oversimplifying the science. This project demonstrates how a structured brand system can support complex clinical information while strengthening market confidence and long-term scalability.
In pharmacogenomics, trust is everything.
Design must communicate precision, clarity, and credibility without oversimplifying the science. This project demonstrates how a structured brand system can support complex clinical information while strengthening market confidence and long-term scalability.
The logo was designed as a precise, typographic mark,
reflecting scientific rigor, clarity, and structured innovation.
reflecting scientific rigor, clarity, and structured innovation.


















❝ Philippe’s structured approach helped our brand stand out
in a crowded biotech space, bringing clarity
and confidence in our presentation.❞
in a crowded biotech space, bringing clarity
and confidence in our presentation.❞

Need a brand that builds trust & drives innovation in biotech & healthcare?



















